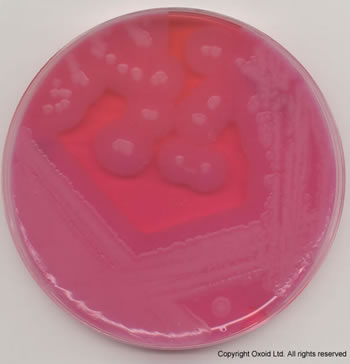
蜡样芽孢杆菌在myp琼脂平板上的生长:对食品中的蜡状芽孢杆菌进行计数
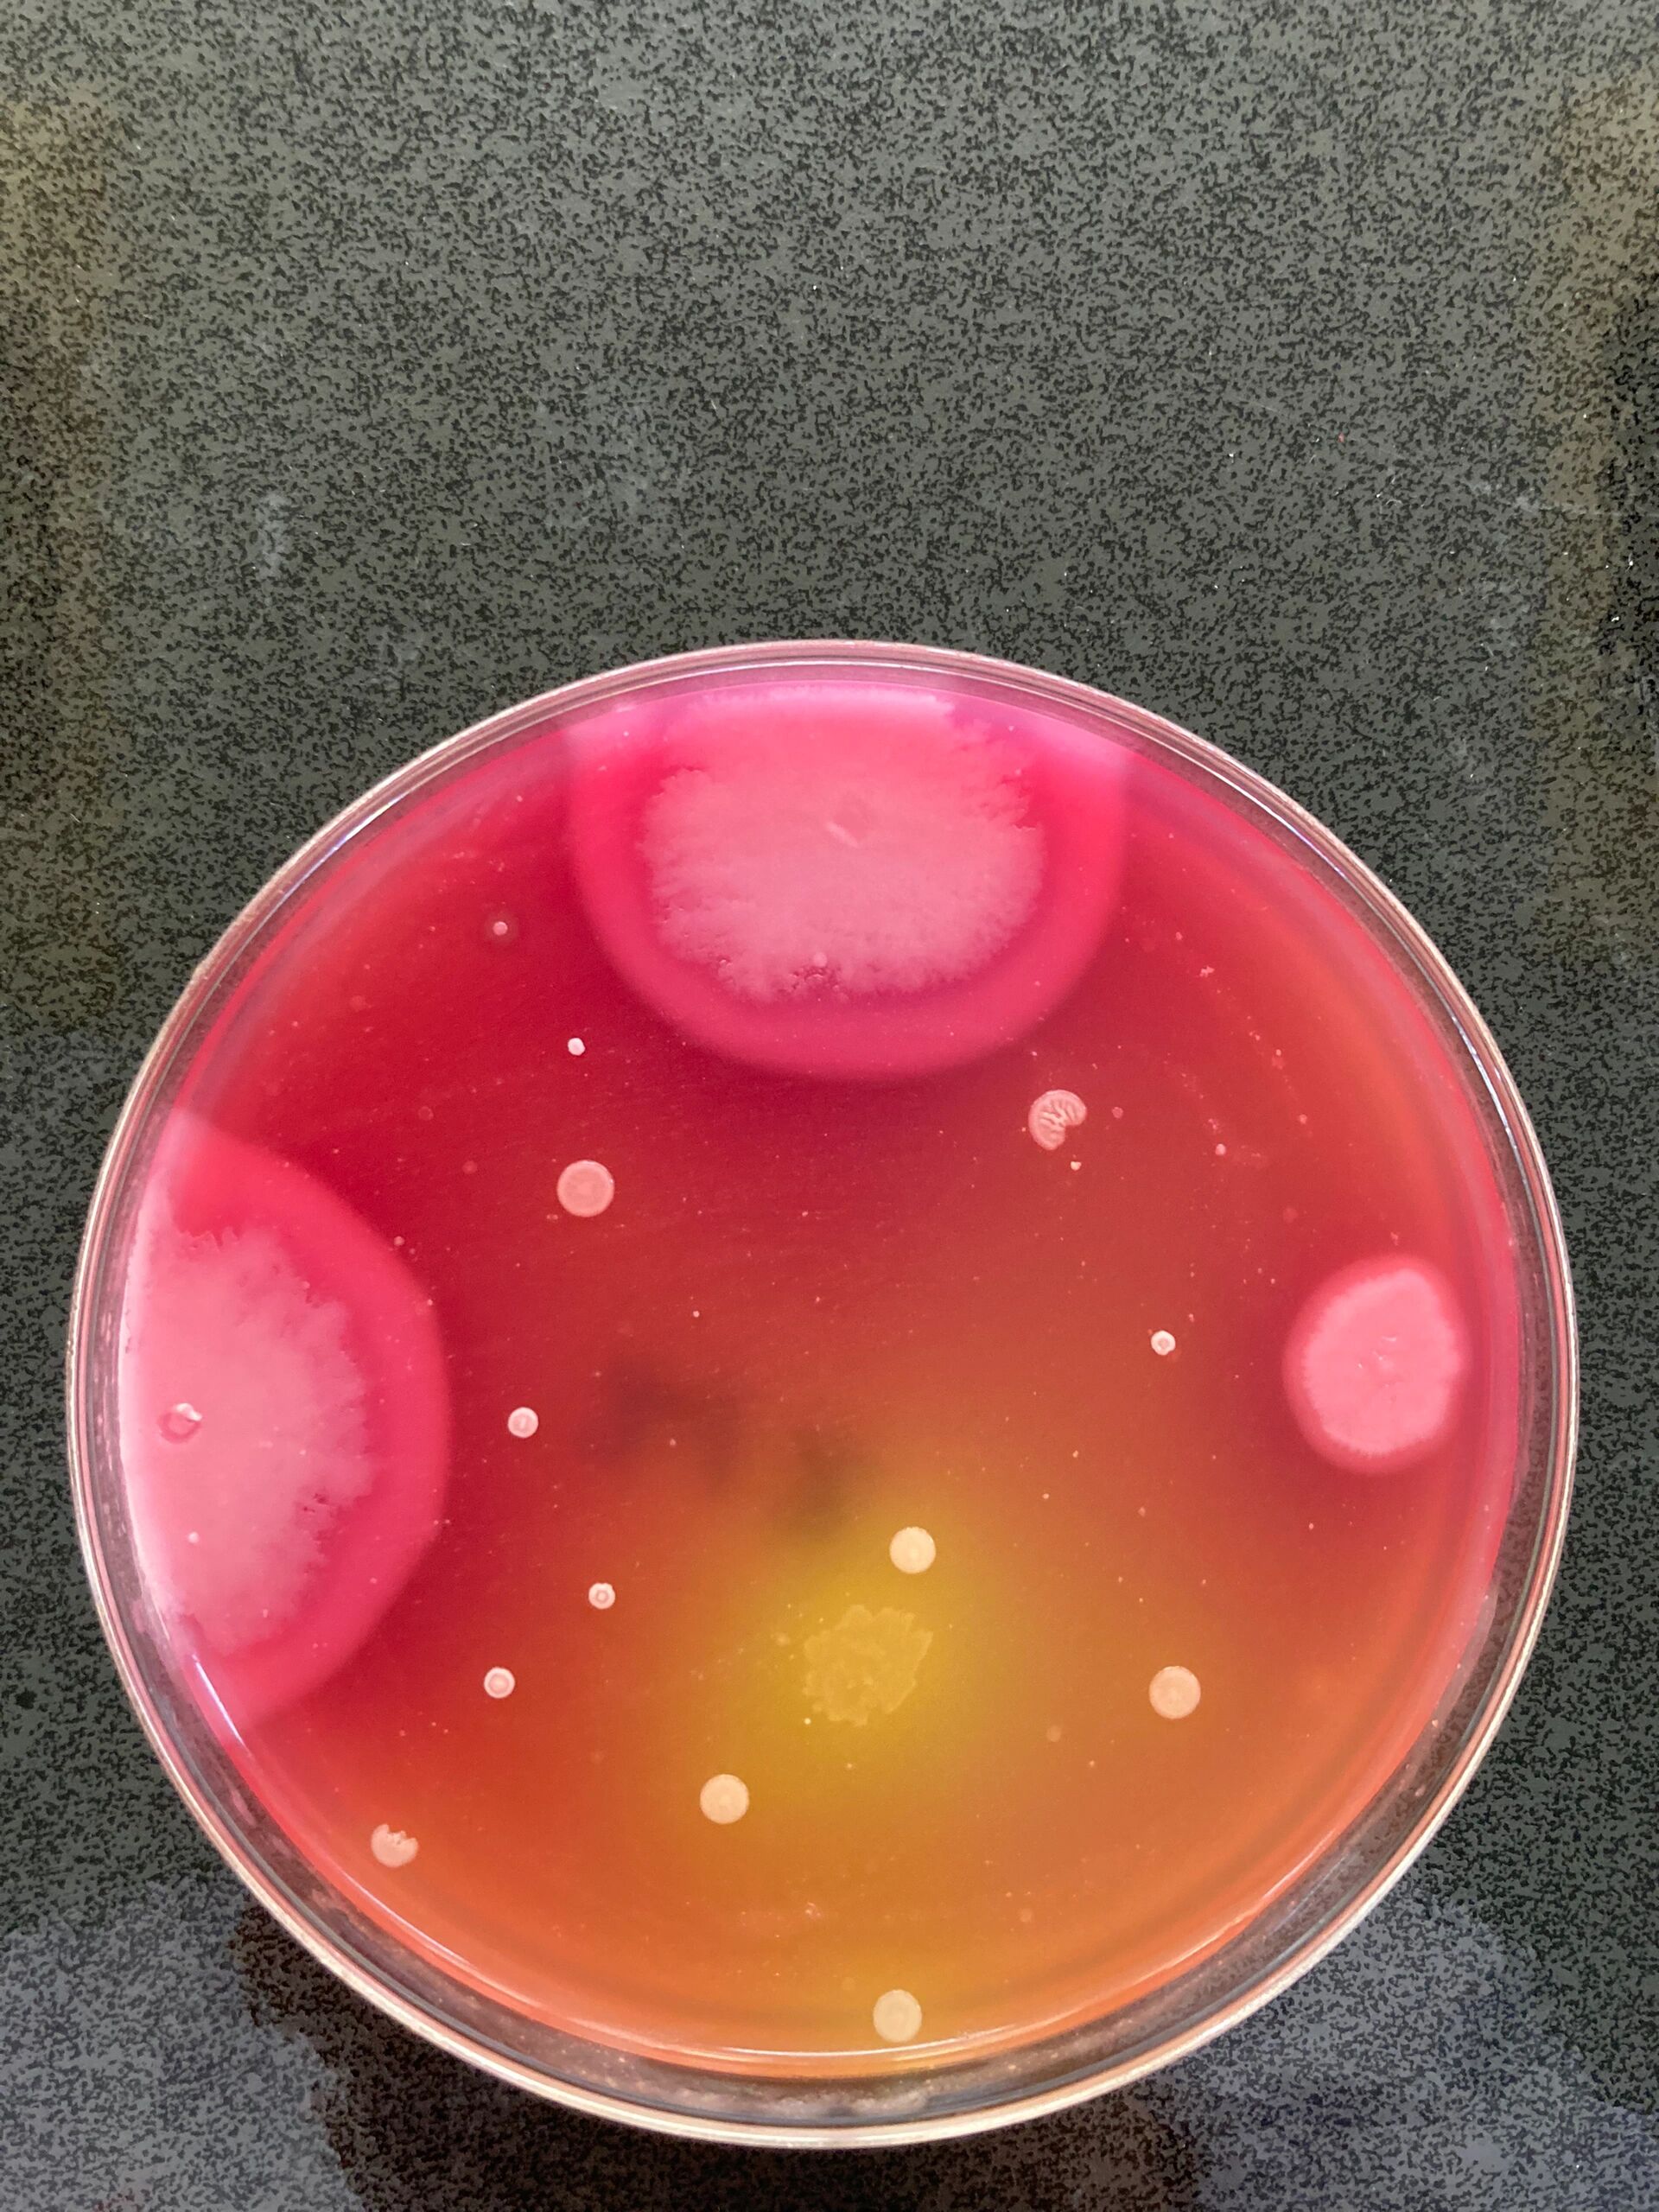
更加典型  br>蜡样芽孢杆菌myp平板蜡样芽胞杆菌分离在myp琼脂平板上
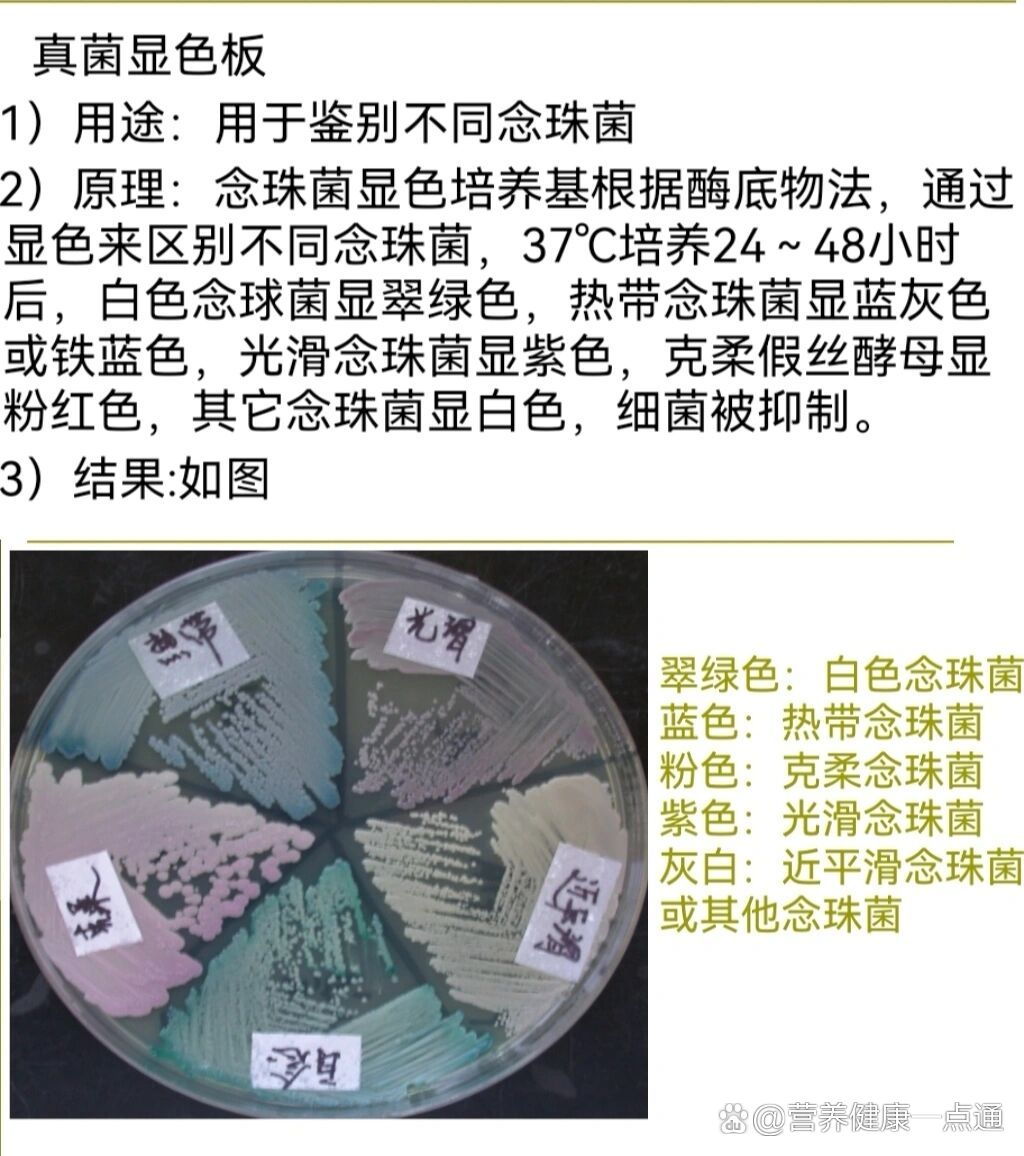
br>97蜡样芽孢杆菌和枯草芽孢杆菌接种血平板和myp平板看结果 /p>
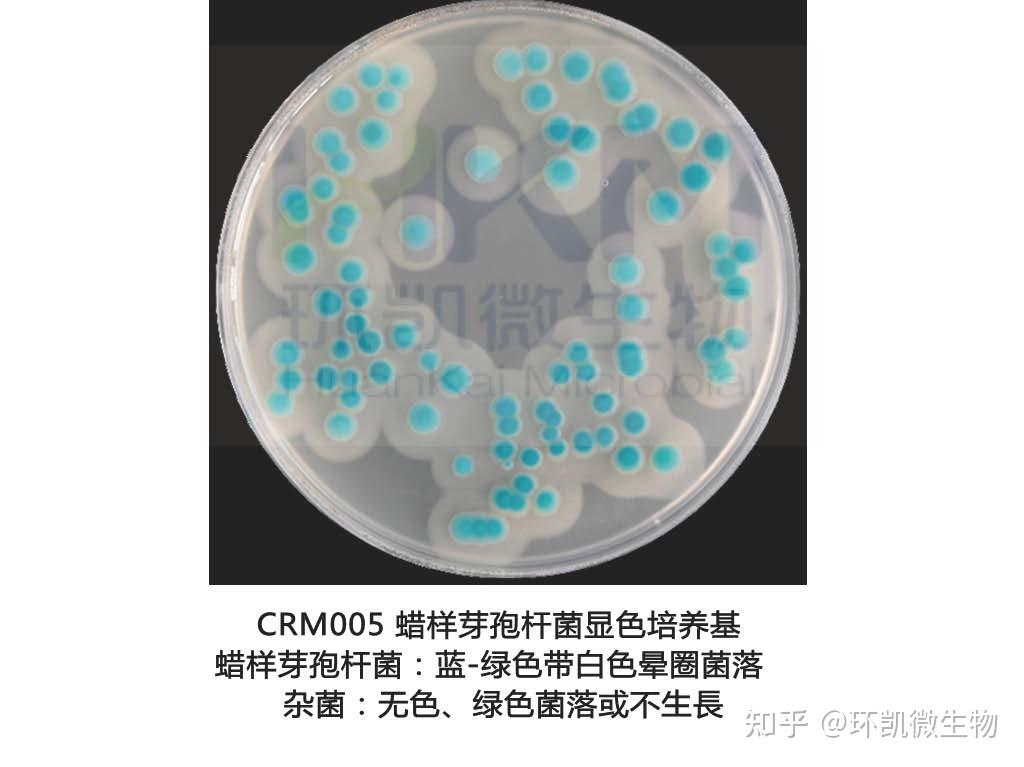
二,蜡样芽孢杆菌的培养特点
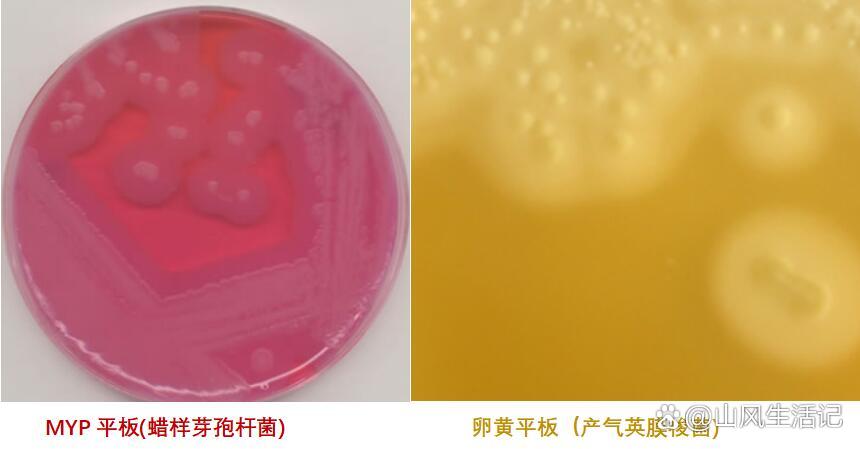
卵黄的作用及使用注意事项-化验员证书培训

蜡样芽孢杆菌MYP

采用快速显色培养基检测蜡样芽孢杆菌更具优势
图片尺寸372x320
蜡样芽孢杆菌在myp琼脂平板上的生长:对食品中的蜡状芽孢杆菌进行计数
图片尺寸350x364
化妆品行业|面膜检出蜡样芽孢杆菌竟与它有关?
图片尺寸450x900
求助恳请大神们帮忙看下这个是蜡样芽孢杆菌吗
图片尺寸675x900
更加典型 br>蜡样芽孢杆菌myp平板蜡样芽胞杆菌分离在myp琼脂平板上
图片尺寸1920x2560
蜡样芽孢杆菌平板计数检验步骤及产品信息
图片尺寸304x296
【求助】恳请大神们帮忙看下这个是蜡样芽孢杆菌吗?
图片尺寸675x900
一日一菌蜡样芽孢杆菌
图片尺寸1080x1424
甘露醇卵黄多粘菌素琼脂基础(myp)用于蜡样芽孢杆菌的固体平板
图片尺寸1500x1500
采用快速显色培养基检测蜡样芽孢杆菌更具优势
图片尺寸618x649
br>97蜡样芽孢杆菌和枯草芽孢杆菌接种血平板和myp平板看结果 /p>
图片尺寸1024x1156
二,蜡样芽孢杆菌的培养特点
图片尺寸1024x767
关于蜡样芽孢杆菌的检验,请各位帮忙看一下
图片尺寸894x810
蜡样芽胞杆菌
图片尺寸800x600
关于蜡样芽孢杆菌的检验,请各位帮忙看一下
图片尺寸1132x1060
蜡状芽孢杆菌蕈状变种
图片尺寸1600x1200
卵黄的作用及使用注意事项-化验员证书培训
图片尺寸860x449
有没有大神做过蜡样枝芽孢杆菌的实验
图片尺寸675x900
myp 菌落 蜡样芽孢杆菌 朋友 琼脂
图片尺寸640x480
推荐甘露醇卵黄多粘菌素琼脂基础(myp)br25o0g干粉型蜡样芽孢杆菌
图片尺寸800x800